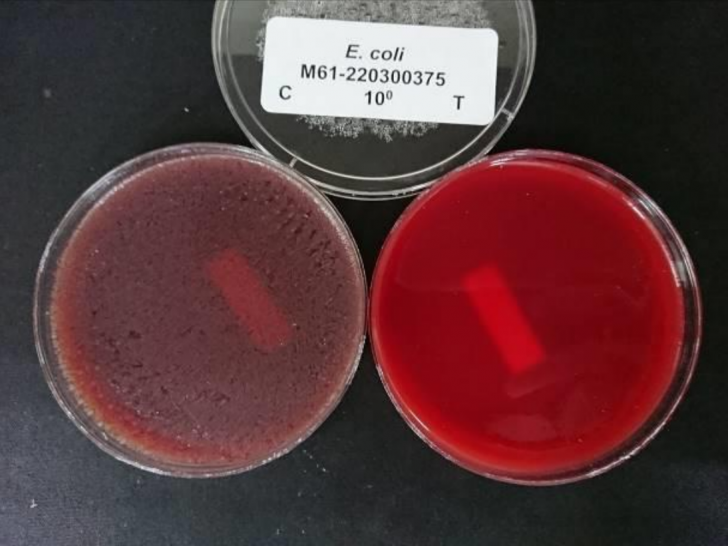
ประจุไฟฟ้าไอออน คืออะไร ? เกิดขึ้นได้อย่างไร ? มันช่วยกำจัดเชื้อโรค และกำจัดฝุ่น PM 2.5 ได้อย่างไร ?

ประจุไฟฟ้าไอออน คืออะไร ? เกิดขึ้นได้อย่างไร ? มันช่วยกำจัดเชื้อโรค และกำจัดฝุ่น PM 2.5 ได้อย่างไร ?

 เคนชิน
เคนชินประจุไฟฟ้าไอออน คืออะไร ? เกิดขึ้นได้อย่างไร ?
มันช่วยกำจัดเชื้อโรค และกำจัดฝุ่น PM 2.5 ได้อย่างไร ?
ในยุคที่ ฝุ่นละอองขนาดเล็ก PM 2.5 แวะเวียนมาเยี่ยมเยือนเราอยู่บ่อย ๆ รวมถึงการระบาดของ เชื้อไวรัสโควิด-19 (COVID-19) ที่มีทีท่าจะทุเลาเบาบางลง แต่ก็ยังมีผู้ติดเชื้อรายใหม่ ๆ ในทุกวัน บวกกับเชื้อไข้หวัดต่าง ๆ ที่มีอยู่มากมายหลายชนิด และมีการพัฒนาสายพันธุ์ใหม่ ๆ อยู่ตลอดเวลา ทำให้การดูแลสุขภาพอนามัยส่วนตัว ยิ่งมีความจำเป็นมากขึ้นเรื่อย ๆ
และในวันนี้เราจะพาคุณผู้อ่านมารู้จักกับเทคโนโลยี (ที่ไม่ได้ใหม่แล้ว แต่มีความน่าสนใจ) อย่างการกำจัดเชื้อโรค และฝุ่น PM 2.5 ในสถานที่อยู่อาศัยด้วย ประจุไฟฟ้าไอออน (Ionic Charge) ที่มีความปลอดภัย และมีประสิทธิภาพสูง เรื่องราวจะเป็นอย่างไร เรามาติดตามไปพร้อม ๆ กันครับ
อะตอมคืออะไร ?
(What is an Atom ?)
ก่อนที่เราจะทำความเข้าใจได้ว่า ประจุไฟฟ้าไอออนคืออะไร ? และมันฆ่าเชื้อโรคได้อย่างไร ? เราจะต้องมาทำความเข้าใจกันก่อนว่า อะตอม (Atom) คืออะไร ? โดยอธิบายให้ฟังแบบเข้าใจง่ายดังนี้ครับ

โครงสร้างของอะตอม
ขอบคุณภาพประกอบจากเว็บไซต์ วิทยาลัยเทคโนโลยีและอุตสาหกรรมการต่อเรือนครศรีธรรมราช
อะตอม เป็นหน่วยพื้นฐานของสสาร ประกอบด้วยส่วนของ นิวเคลียส (Nucleus) ที่มีความหนาแน่นมากอยู่ในแกนกลางของอะตอม ซึ่งในนิวเคลียสมีส่วนประกอบสำคัญอยู่ 2 อย่างคือ โปรตรอน (Proton) หรือตัว p ในภาพ โดยที่โปรตรอนมีสถานะทางไฟฟ้าเป็นขั้วบวก อีกส่วนประกอบที่สำคัญของนิวเคลียส ที่เป็นแกนกลางของอะตอมคือ นิวตรอน (Neutron) หรือตัว n ในภาพ โดยที่นิวตรอนมีสถานะเป็นกลางทางไฟฟ้า (คือไม่ได้เป็นทั้งขั้วบวก และขั้วลบ)
อีกหนึ่งส่วนประกอบที่สำคัญของอะตอมก็คือสิ่งที่เรียกว่า อิเล็กตรอน (Electron) หรือตัว e ในภาพ โดยที่อิเล็กตรอนมีสถานะทางไฟฟ้าเป็นขั้วลบ จะเห็นได้ว่าความพิเศษของอิเล็กตรอนคือ มันคล้ายกับดาวเทียมที่โคจรอยู่รอบ ๆ นิวเคลียสที่อยู่ตรงแกนกลาง
ในการที่ ดาวเทียม หมุนโคจรอยู่รอบ ๆ โลกได้โดยไม่หลุดกระเด็นออกไป เพราะมีแรงดึงดูดของโลกที่กระทำกับดาวเทียม และหากเปรียบเทียบกับอะตอมแล้ว สิ่งที่ดึงดูดให้ อิเล็กตรอน หมุนโคจรอยู่รอบ ๆ นิวเคลียส โดยที่ไม่หลุดกระเด็นไปไหน ก็เพราะมี แรงดึงดูดของไฟฟ้าสถิต (Electrostatic Attraction) ที่เป็นการดึงดูดกันระหว่าง โปรตรอน ที่เป็นไฟฟ้าขั้วบวก ที่อยู่ในแกนกลาง กับ อิเล็กตรอน เป็นไฟฟ้าขั้วลบ ที่หมุนโคจรอยู่โดยรอบ เทียบให้เห็นภาพง่าย ๆ ก็เหมือนกับการที่แม่เหล็กขั้วเหนือ และขั้วใต้ มีแรงดึงดูดระหว่างกัน
ย้อนกลับขึ้นไปดูที่ภาพด้านบนอีกครั้งจะเห็นว่า อะตอมของสสารชนิดนี้ มีจำนวนของ โปรตรอน (ขั้วบวก) อยู่ 2 ตัว ซึ่งเท่ากับจำนวน อิเล็กตรอน (ขั้วลบ) ที่มีอยู่ 2 ตัวเช่นเดียวกัน ทำให้อะตอมของสสารชนิดนี้ มีความเป็นกลางทางไฟฟ้า ทำให้ไม่มีแรงดึงดูดของไฟฟ้าสถิต ที่จะส่งออกไปดูดจับกับอะตอมของสสารอื่น ๆ
ประจุไฟฟ้าไอออน คืออะไร ?
(What is a Negative Charge or Anion ?)

ขอบคุณภาพประกอบจากเว็บไซต์ sciencenotes.org
แล้วอะตอมของสสารที่ไม่มีความเป็นกลางทางไฟฟ้ามีอยู่หรือไม่ ? คำตอบก็คือมีครับ ตามภาพด้านบนเลย โดยที่
- เราเรียกอะตอมที่มีจำนวน โปรตรอน (ขั้วบวก) มากกว่าจำนวน อิเล็กตรอน (ขั้วลบ) ที่หมุนโคจรอยู่รอบ ๆ ว่า Cation (แคตไอออน) หรือ อะตอมที่มีประจุไฟฟ้าไอออนเป็นบวก และสิ่งนี้เองเรียกว่า ประจุไฟฟ้าไอออนบวก
- เราเรียกอะตอมที่มีจำนวน โปรตรอน (ขั้วบวก) น้อยกว่าจำนวน อิเล็กตรอน (ขั้วลบ) ที่หมุนโคจรอยู่รอบ ๆ ว่า Anion (แอนไอออน) หรือ อะตอมที่มีประจุไฟฟ้าไอออนเป็นลบ และสิ่งนี้เองเรียกว่า ประจุไฟฟ้าไอออนลบ
โดยที่ในธรรมชาติแล้ว Cation (หรืออะตอมที่มี ประจุไฟฟ้าไอออนบวก) และ Anion (หรืออะตอมที่มี ประจุไฟฟ้าไอออนลบ) จะมีแรงดึงดูดจากพลังงานไฟฟ้าสถิต (เหมือนแม่เหล็กขั้วเหนือและขั้วใต้ที่สามารถดูดติดกับวัสดุที่เป็นเหล็ก) ทำให้ทั้ง Cation และ Anion สามารถดูดจับกับอะตอมของสสารอื่น ๆ ทำให้โครงสร้างทางเคมีของสสารนั้น ๆ มีคุณสมบัติที่เปลี่ยนไป
ประจุไฟฟ้าไอออนในธรรมชาติ เกิดขึ้นได้อย่างไร ?
(How are Negative Ions formed in nature ?)
ในสภาพอากาศของโลกประกอบไปด้วยก๊าซไนโตรเจน (Nitrogen - N) 78% ออกซิเจน (Oxygen - O) 21% และก๊าซอื่น ๆ อีกประมาณ 1% เมื่อก๊าซเหล่านี้อยู่ในชั้นบรรยากาศ จะมีลักษณะที่เป็นกลางทางไฟฟ้า (คือไม่มีแรงดึงดูดของพลังงานไฟฟ้าสถิต) แต่ในโลกของเราที่แสงแดดจากดวงอาทิตย์ได้ส่ง รังสีแอลฟา (Alpha Ray) รังสีเบตา (Beta Ray) และรังสีแกมมา (Gamma Ray) ผ่านชั้นบรรยากาศเข้ามาสู่โลก ทำให้ประจุของก๊าซบางตัว เปลี่ยนสภาพกลายเป็น ประจุไฟฟ้าไอออนลบ หรือ Anion (มีจำนวนอิเล็กตรอนมากกว่าโปรตรอน) ทำให้เเกิดแรงดูดจากพลังงานไฟฟ้าสถิต
นอกจากนี้ การเกิดฟ้าผ่า (Lightning) ก็เป็นอีกกระบวนการหนึ่งในธรรมชาติที่ทำให้เกิด ประจุไฟฟ้าไอออนลบ และอีกวิธีการหนึ่งในธรรมชาติที่ทำให้เกิดประจุไฟฟ้าไอออนลบคือ การที่น้ำเคลื่อนตัวกระทบเข้ากับชายหาดทะเลหรือโขดหิน ทำให้บริเวณชายหาด และน้ำตก เป็นสถานที่ที่มีประจุไฟฟ้าไอออนลบอยู่เป็นจำนวนมาก และอีกหนึ่งแหล่งผลิตประจุไฟฟ้าไอออนลบที่สำคัญคือต้นไม้ ที่สามารถเปลี่ยนอนุภาคของก๊าซออกซิเจน ให้กลายเป็นไอออนลบ โดยที่ต้นไม้แต่ละประเภท มีความสามารถในการผลิตไอออนลบในระดับที่แตกต่างกัน
ประจุไฟฟ้าไอออน กำจัดฝุ่น PM 2.5 และฆ่าเชื้อโรคได้อย่างไร ?
(How does Negative Ions remove PM 2.5 and kill virus ?)
ประจุไฟฟ้าไอออนลบ หรือ Anion ที่ล่องลอยอยู่ในอากาศ และมีแรงดึงดูดจากพลังงานไฟฟ้าสถิต จะสามารถดูดจับกับอนุภาคอื่น ๆ ในอากาศ อย่างเช่นฝุ่น PM 2.5 ทำให้ฝุ่นมีน้ำหนักมากขึ้นและตกลงสู่พื้น ทำให้ฝุ่น PM 2.5 ในอากาศมีปริมาณที่ลดลง และเราสามารถกำจัดฝุ่น PM 2.5 ที่อยู่บนพื้นทิ้งได้โดยการกวาดพื้น หรือดูดฝุ่น

ขอบคุณภาพประกอบจากเว็บไซต์ iso-aire.com
ในส่วนของการกำจัดเชื้อไวรัส เป็นการทำงานของ ประจุไอออนลบ และประจุไอออนบวก ที่ล่องลอยอยู่ในอากาศ (มีเครื่องฟอกอากาศที่สามารถผลิตได้ทั้ง ประจุไอออนลบ และบวก) โดยประจุไอออนทั้ง 2 รูปแบบนี้ สามารถดึงไฮโดรเจนออกจากส่วนของโปรตีน ที่ห่อหุ้มผิวของเซลล์เชื้อไวรัสอยู่ ทำให้เชื้อไวรัสสูญเสียคุณสมบัติในการที่จะทำให้เราติดเชื้อ โดยเซลล์ของเชื้อไวรัสที่สูญเสียไฮโดรเจน จะไม่สามารถยึดเกาะกับเซลล์ของสิ่งมีชีวิตอื่นได้อีกต่อไป

ขอบคุณภาพประกอบจากเว็บไซต์ iso-aire.com
ในส่วนของการกำจัดแบคทีเรีย และเชื้อเรา ประจุไอออนลบ และบวกที่ล่องลอยอยู่ในอากาศ สามารถดึงไฮโดรเจนออกมาจากเซลล์ของแบคทีเรีย และเชื้อเรา ทำให้เซลล์เกิดการฉีกขาด และเชื้อโรคจะตายลง ช่วยลดความเสี่ยงในการแพร่เชื้อทางอากาศ
เราสามารถสร้างประจุไฟฟ้าไอออน ได้หรือไม่ ?
(Can we generate a Negative Ion ?)
ด้วยความที่มนุษย์เริ่มมองเห็นคุณประโยชน์ของ ประจุไฟฟ้าไอออน ที่สามารถเกิดขึ้นได้เองในแหล่งที่มีความเป็นธรรมชาติอยู่สูง ไม่ว่าจะเป็น ชายหาด ป่าเขา น้ำตก แต่หาได้ยากในสภาพความเป็นอยู่ของคนเมือง ทำให้มีผู้ผลิตเครื่องใช้ไฟฟ้าหลายราย ได้ใส่เทคโนโลยีการสร้างประจุไฟฟ้าไอออน ลงไปในเครื่องปรับอากาศ หรือ เครื่องฟอกอากาศ (Air Purifier) โดยมักจะเรียกฟังก์ชันการปล่อยประจุไฟฟ้าไอออน ว่าเป็น Ionizer, Ion หรือ Anion

Bionic Cube เป็นตัวอย่างที่น่าสนใจของเครื่องฟอกอากาศ
ที่ใช้เทคโนโลยีระดับสูงในการปล่อยประจุไอออนทั้ง ประจุลบ และประจุบวก
ไม่ใช่ว่าเครื่องฟอกอากาศที่ใช้เทคโนโลยีการปล่อยประจุไอออน จะมีแต่ข้อดีเพียงอย่างเดียว มันยังมีจุดอ่อนที่ต้องพิจารณาคือ เครื่องฟอกอากาศที่ใช้หลักการปล่อยประจุไอออนบางรุ่น จะมีการสร้างก๊าซโอโซน (O3) จากการทำงานของมันด้วย ซึ่งโอโซนถือว่าเป็นก๊าซพิษ (ปกติแล้วโอโซนอยู่ในชั้นบรรยากาศ ห่อหุ้มโลกให้ปลอดภัยจากรังสีต่าง ๆ ที่มาจากดวงอาทิตย์)
และการสูดดมก๊าซโอโซน ก็เป็นอันตรายต่อระบบทางเดินหายใจ โดยที่เครื่องฟอกอากาศแบบปล่อยประจุไอออน แต่ละรุ่น แต่ละยี่ห้อ จะมีอัตราการปล่อยโอโซนที่มากน้อยแตกต่างกัน (ยิ่งปล่อยน้อยยิ่งดี) การเลือกซื้อเครื่องฟอกอากาศแบบปล่อยประจุไอออน ควรพิจารณาถึงเรื่องนี้ด้วย

เครื่องฟอกอากาศ Bionic Cube ได้ใบรับรองจาก Haldeman Services LLC รับรองว่าไม่ปลดปล่อยโอโซนจากการทำงาน
ด้วยเหตุผลดังกล่าวข้างต้น ทำให้ เครื่องฟอกอากาศแบบปล่อยประจุไอออน ที่ไม่มีการปลดปล่อยโอโซน กลายเป็นของที่มีความโดดเด่นขึ้นมา ตัวอย่างเช่น เครื่องฟอกอากาศขนาดพกพา Bionic Cube ที่มีหลักการทำงานแบบการปล่อยประจุไอออน และได้ผ่านการทดสอบจากสถาบันที่น่าเชื่อถือ โดยได้ใบรับรองว่าไม่มีการปล่อยโอโซน หรือ "การปลดปล่อยโอโซนเป็นศูนย์" (Zero Ozone Emissions) โดยไม่พบการปล่อยโอโซนเกินกว่าระดับ 0.005 ppm (Part Per Million หรือ หนึ่งส่วนในล้านส่วน) ทำให้ไม่มีการปลดปล่อยก๊าซโอโซนที่เป็นผลเสียต่อสุขภาพ
ภาพผลการทดสอบฆ่าเชื้อแบคทีเรีย E. coli ของเครื่องฟอกอากาศ Bionic Cube
ที่ทำโดยห้องทดสอบของ Super Laboratory Co., Ltd.
ภาพด้านบนนี้ เป็นผลการทดสอบโดย ห้องทดสอบที่น่าเชื่อถือของบริษัท Super Laboratory Co., ltd. ยืนยันว่า เครื่องฟอกอากาศ Bionic Cube สามารถกำจัดเชื้อแบคทีเรีย Escherichia coli (E. coli หรือ เชื้ออีโคไล) ได้เกินกว่า 99.99% จริง (Bacteriacidal Activities : >99.99%) โดยใช้ระยะเวลาในการทดสอบ 24 ชั่วโมง
โดยที่ภาชนะทางด้านซ้าย (ตามภาพด้านบน) เป็นเชื้อแบคทีเรีย E. coli ที่ไม่ได้ผ่านการฆ่าเชื้อ โดยปล่อยไว้เฉย ๆ เป็นเวลา 24 ชั่วโมง หรือที่เรียกว่าเป็น Control Group ของการทดสอบ
และในส่วนของภาชนะทางด้านขวา เป็นเชื้อแบคทีเรีย E. coli ที่ผ่านการฆ่าเชื้อด้วย Bionic Cube โดยการเปิดให้เครื่องทำงานเป็นเวลา 24 ชั่วโมง หรือหรือที่เรียกว่าเป็น Test Group ของการทดสอบ
จะสังเกตเห็นได้ว่ามีความแตกต่างอย่างชัดเจน โดยผลการทดสอบสรุปออกมาว่า Bionic Cube สามารถกำจัดเชื้อแบคทีเรีย E. coli ได้เกินกว่า 99.99% จริง
นอกจากนี้ ทางผู้ผลิตเครื่องฟอกอากาศ Bionic Cube ก็ยังเคลมว่า มีความสามารถในการกำจัดเชื้อไวรัสโควิด-19 ทั้งที่ล่องลอยอยู่ในอากาศ และที่เกาะอยู่ตามพื้นผิวต่าง ๆ
ที่มา : www.dailygizmo.tv , th.wikipedia.org , th.wikipedia.org , www.iso-aire.com , sites.google.com
 คำสำคัญ »
คำสำคัญ »
|
|
ไม่เสพติดไอที แต่ชอบเสพข่าวเทคโนโลยี หาความรู้ใหม่ๆ มาใส่สมอง |

ทิปส์ไอทีที่เกี่ยวข้อง

แสดงความคิดเห็น


 ซอฟต์แวร์
ซอฟต์แวร์ แอปพลิเคชันบนมือถือ
แอปพลิเคชันบนมือถือ เช็คความเร็วเน็ต (Speedtest)
เช็คความเร็วเน็ต (Speedtest) เช็คไอพี (Check IP)
เช็คไอพี (Check IP) เช็คเลขพัสดุ
เช็คเลขพัสดุ สุ่มออนไลน์
สุ่มออนไลน์





















